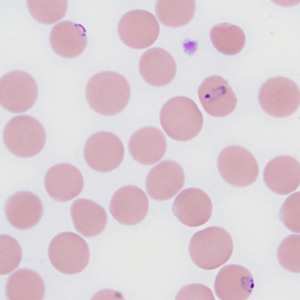
November - 2010 - Case #287

2010 DPDx Case Studies
DPDx Case Studies – 2010
December 2010
November 2010
October 2010
September 2010
August 2010
July 2010

A 35-year-old woman went to her health care provider with complaints of abdominal pain, cramps and diarrhea. She told her doctor that she had recently returned from a business trip to Mexico. Stool was collected in 10% formalin and polyvinyl alcohol (PVA) for routine ova-and-parasite (O&P) examination.
June 2010

DPDx is moving! Along with the all of the laboratories within the Division of Parasitic Diseases and Malaria at the CDC! We want to take this opportunity to let you know that although actual specimen receiving and testing will be temporarily interrupted for about a week or two, DPDx will continue to provide telediagnosis assistance via the internet.
May 2010
April 2010
March 2010
February 2010
January 2010
DPDx is an educational resource designed for health professionals and laboratory scientists. For an overview including prevention, control, and treatment visit www.cdc.gov/parasites/.